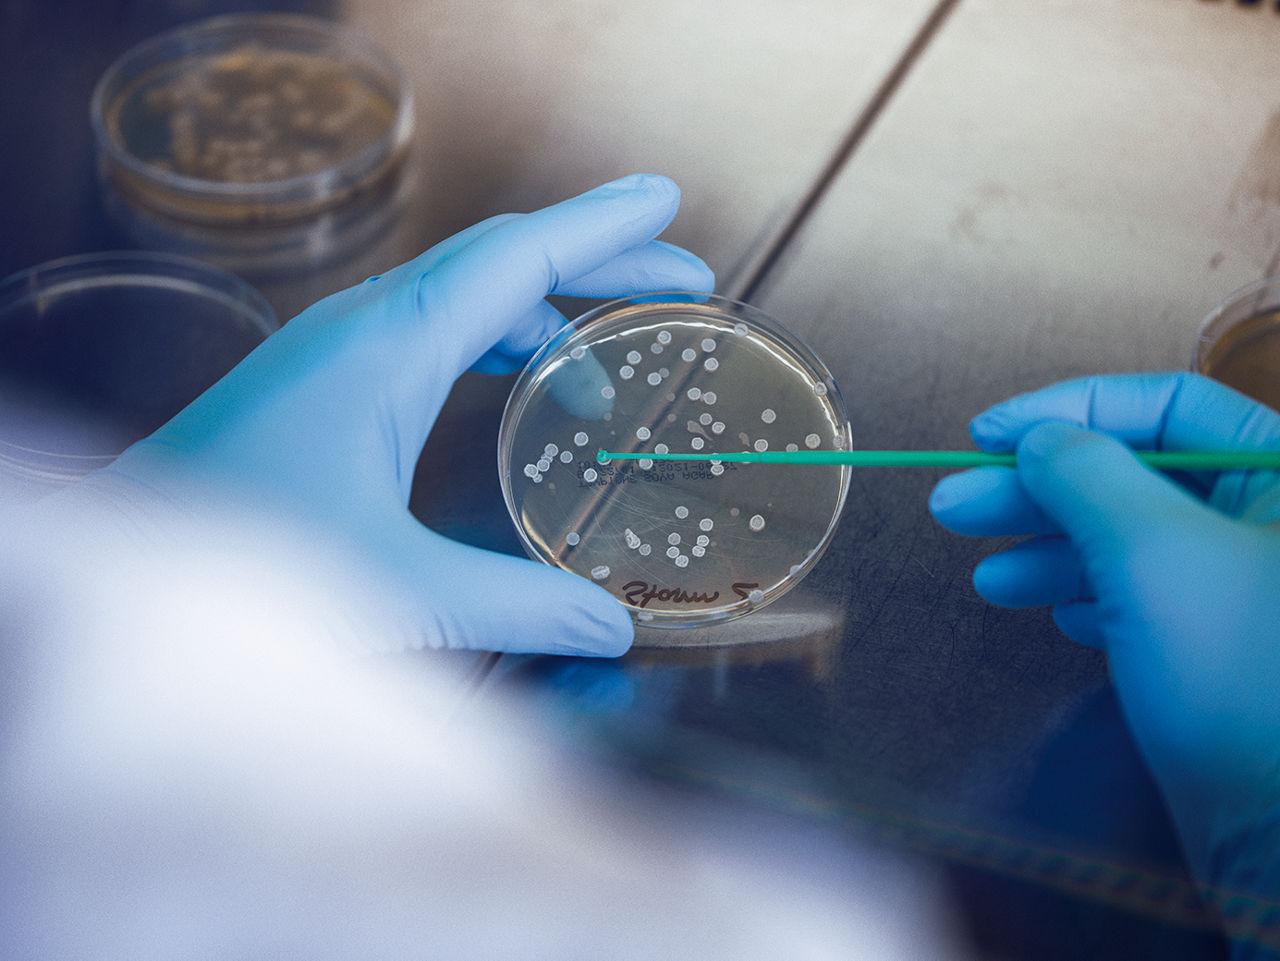
Gloved hands take samples from a Petri dish using a swab.

We need our gut, and our gut needs us.” That’s how Dr. Heike tom Dieck describes this vital connection, because intestinal health plays a significant role in well-being. “It’s the key to our overall health—for our supply of nutrients, the immune system, our metabolic functions, and our psyche,” says Dr. tom Dieck, a nutritionist who carries out research for Evonik in Hanau. Her goal is to find out the characteristics of the microorganisms that have a positive influence on the equilibrium in our intestines.
A balanced diet that is rich in fiber is known to be a precondition for this equilibrium. When fiber is broken down by bacteria inside the large intestine, one of the substances that are generated is butyrate, a short-chain fatty acid that plays a special role. tom Dieck and her team took the following insight as their starting point: “Butyrate provides most of the energy that is needed by some intestinal cells. Scientific studies have shown that this substance is essential for a healthy intestinal mucosa and an effective local immune system.” If there is a lack of butyrate in the intestines, it is difficult for the intestinal mucosa to fulfill its function as a protective barrier.
Using this approach, the research team found a way to increase the formation of butyrate by the intestinal bacteria by bringing together a live probiotic bacterial strain and a protein component. Tests have shown that each ingredient used by itself already boosts the formation of butyrate by the bacteria, says tom Dieck. “However, when the ingredients are used in combination they have an even bigger effect,” she says. Experts call this kind of synergetic interplay “synbiotic.”
This research-based development has now led to an innovative system solution for business customers who want to market applications for maintaining gut equilibrium. “In addition to the research, we provide all the ingredients as well as target group-specific positioning,” says tom Dieck, who is the head of research and business development for synbiotics at Evonik. “The advantage provided by our formulations is that they enable companies to make not only innovative combinations but also reliable assertions about a specific health benefit—in other words, health claims—in their communication with consumers.”

Up to 100 TRILLION
bacteria and fungi are estimated to form the human microbiome
That’s a fairly significant aspect, and the team conducts its own field trials to support it. “The regulatory environment in the area of dietary supplements is very complex,” says tom Dieck. “For example, in the EU companies are not allowed to make health-related statements about probiotic bacteria without further ado.” However, additional ingredients make it possible to explain the potential usefulness of the product more clearly.
DIVERSIT Y PROMOTES HEALTH
The colleagues researching the microbiome and gut health in the district of Halle-Künsebeck in Westphalia, Germany, are playing an important role in the development of synbiotics. The microbiologist Prof. Stefan Pelzer has been researching microorganisms in the digestive tract since 2013. His focus was initially on the question of how livestock can be kept healthy and productive without antibiotics. Today his team is also researching the human microbiome—inside the gut and on the skin.
“Today scientists are discovering that about 90 percent of all illnesses have a connection with the gut microbiome,” he says. The number of bacterial cells in the human body exceeds the number of the body’s own cells by a factor of 1.3—and most of these bacterial cells are located in the large intestine. This might make some people feel uncomfortable. But according to Pelzer, it would be disconcerting if the opposite were the case. “The composition of the microbiota—in other words, the assemblage of microorganisms—is altered by many illnesses as well as by the aging process,” he says. “Specifically, the diversity of the gut bacteria decreases.” This occurs alongside a loss of the products of bacterial metabolism, such as butyrate, that are necessary for human health. “Researchers are increasingly documenting the fact that a decrease in the diversity of the microbiome has a negative effect on the body’s fitness and its resistance to infection,” Pelzer explains.
Consequently, those who aim to enhance high performance and resilience in human beings and animals often do so by adapting the microbiome—for example, by means of probiotic products, which contain live bacteria. These products generate multifaceted momentum, either directly by forming substances such as lactic acid or indirectly by influencing the composition of the microbiome.

The chicken gut model
The chicken gut model consists of up to five glass vessels connected by tubes and pipes, reagents, and measuring instruments. It has been available to Evonik researchers in Halle-Künsebeck since 2018. This unique simulation was developed as part of the GOBI (Good Bacteria and Bioactives in Industry) innovation alliance funded by the German Federal Ministry of Education and Research. Each stage of the digestive tract and its specific environment is represented by a glass vessel. Connected in a series, they simulate the processes in the entire digestive system. The bacteria encounter gastric acids, bile salts, enzymes that break down nutrients, competing microbes, and other stress factors—in a natural sequence and over a realistic period of time. The researchers can sample at every point in order to observe how the local conditions influence the probiotic bacteria and vice versa.

The first probiotic developed in-house by Evonik was meant for chickens. Probiotics reinforce the balanced composition and resilience of the natural microbiome, and that prevents colonization by pathogenic bacteria such as Clostridium perfringens. This pathogen causes immense economic damage in poultry farming all over the world. The Evonik product GutCare®, which contains a strain of Bacillus subtilis, is meant to reduce the use of antibiotics as preventive components of chicken feed. It has been marketed successfully in the USA, China, India, and other countries since 2017.
However, Pelzer was not satisfied with merely proving the effectiveness of this product in a petri dish and a feed test. He wanted to have a more precise understanding of exactly what happens in which part of a chicken’s gut. To gain this information, he needed a model that simulates a chicken’s gut and the physiological processes inside it. Researchers are especially interested in finding out whether gastric acid and pancreatic juice inhibit probiotic products and how they change the composition of the gut microbiome. Do these acids increase or decrease microbiome diversity? Is there a shift in the percentages of characteristic groups of bacteria? And is there increased formation of short-chain fatty acids such as butyrate?
At least 1,000 SPECIES
of bacteria can be found in the human digestive tract
All of these questions can be answered by means of genome sequencing. In this process, all the genes in a bacterial sample taken from the gut model are analyzed. “Twenty years ago, this kind of analysis would have cost tens of thousands of US dollars and required many months of work,” says Pelzer. “Today we can get this analysis done for a few hundred dollars in a few weeks. For very specific inquiries, we can even get it done on site in real time.”
Computational biologists can use these data to create a rough picture of the distribution of the existing groups of bacteria and to identify possible changes. They can even use the gene sequences to find out what capabilities a microbiota has—for example, whether it is producing certain metabolites, which are the intermediate products of a biochemical metabolic pathway.
MODELS ENABLE PREDICTIONS
The expertise gained in Halle-Künsebeck can flow into the development of new probiotics for human beings and animals. “By now our models are so good that they enable us to make very reliable predictions about our products’ behavior in a living organism,” says Pelzer. That speeds up the development process and reduces the need for tests in live animals.
This is also true of the synbiotic product concepts that Heike tom Dieck and her team are pursuing. The initial findings came from stool samples that had been cultivated together with bacterial strains and selected substances. Next, they investigated how the microbiota composition had changed and what metabolic products were present. “Even in this simple model we already saw clear effects on some substances and some bacteria,” says tom Dieck. “The composition of the microbiome changed, and we found more butyrate.” For some combinations of a bacterium and a substance, the effect was even more intense.

The combination of probiotic bacterium and dipeptide that is used obviously influences the microbiome in favor of the butyrate-forming bacterial strains. “This substance is produced in different ways by the various groups of gut bacteria,” tom Dieck explains. “This is where evolution probably wanted to take the safest route.” The gut microbiome differs from one individual to the next, and it’s also influenced by a person’s lifestyle. Nonetheless, numerous further tests show that the combination of Bacillus subtilis and a peptide consisting of two amino acids leads to increased butyrate values. However, this result is only possible if the dipeptide and the bacterium simultaneously reach the entrance to the large intestine, where butyrate-forming bacteria are located.
Up to 2 KILOGRAMS
of microbial biomass can be found in every human being
The researchers realized that it’s crucial to ensure the protected transportation of these substances through the digestive tract. They found a solution for this problem in-house: the EUDRAGUARD ® biotic protective coating developed by Evonik for dietary supplements. This capsule “recognizes” the transition from the small intestine to the large intestine by means of the increase in the pH value, dissolves at this precise point, and releases its contents exactly where they are needed.
ELEMENTS-Newsletter
Receive exciting insights into Evonik's research and its social relevance - conveniently by e-mail.
INDIVIDUALIZED SOLUTIONS
The synbiotics researchers used a model similar to the chicken gut model in Halle-Künsebeck to precisely understand the behavior of the capsules containing the bacterium and the dipeptide in the human digestive tract. They showed that the bacterium and the dipeptide reach the target destination in the large intestine, and that their arrival correlates with an increase of the local butyrate-forming bacteria. This has now been confirmed by a small pilot study in human beings.
However, for the research teams at Evonik this topic is still far from being exhausted. They are continuing their work on further probiotic and synbiotic developments. The individualized nature of the gut and its equilibrium leads to many further questions. For example, are there ways to determine the current status of an individual’s gut—and to make a targeted and individualized intervention with the help of microbiota? If this approach succeeds, it will open up many new opportunities for research and practical applications.



